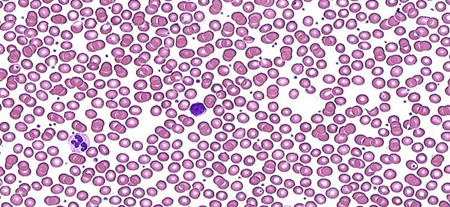

Resumo
Diagnósticos diferenciais
comuns
- Trauma
- Hemorragia gastrointestinal aguda
- Ruptura de aneurisma vascular
- Cirurgia
- Menorragia
- Deficiência de ferro
- Deficiência de vitamina B12
- Deficiência de folato
- Síndrome mielodisplásica
- Leucemia linfoide aguda
- Leucemia mieloide aguda
- Leucemia mieloide crônica
- Leucemia de células pilosas
- Anemia aplásica adquirida
- Infiltração por malignidade secundária
- Aplasia pura de série vermelha
- Toxicidade medicamentosa
- Anemia de doença crônica
- Doença renal crônica
- Doença hepática crônica
- Gestação
Incomuns
- Desnutrição generalizada
- Quimioterapia citotóxica
- Radioterapia
- Abuso de álcool
- Intoxicação por chumbo
- Hipotireoidismo
- Anemia hemolítica autoimune
- Reação transfusional
- Malária
- Hepatite viral
- Toxoplasmose
- Leishmaniose
- Infecção por parvovírus B19
- Mononucleose infecciosa
- Citomegalovírus (CMV)
- Anemia falciforme
- Talassemias
- Esferocitose hereditária
- Deficiência de glicose-6-fosfato desidrogenase (G6PD)
- Síndromes de falência medular
- Síndrome hemolítico-urêmica
- Coagulação intravascular disseminada (CIVD)
- Púrpura trombocitopênica trombótica
- Hemangioma
- Hipertensão maligna
- Superfícies e valvas protéticas
- Queimaduras cutâneas
Colaboradores
Autores
Robert Zaiden, MD
Hematologist Oncologist
Baptist MD Anderson Cancer Center
Jacksonville
FL
Declarações
RZ declares that he has no competing interests.
Agradecimentos
Dr Robert Zaiden would like to gratefully acknowledge Dr Fauzia Rana, a previous contributor to this topic.
Declarações
FR declares that she has no competing interests.
Revisores
Christoph Pechlaner, MD
Associate Professor of Medicine
Innsbruck Medical University
Innsbruck
Austria
Declarações
CP declares that he has no competing interests.
John Densmore, MD, PhD
Associate Professor of Clinical Medicine
Department of Medicine
Division of Hematology/Oncology
University of Virginia
Charlottesville
VA
Declarações
JD declares that he has no competing interests.
Carlos Aravena, MD
Internal Medicine Instructor
Member of Evidence Based Medicine Unit
Catholic University of Chile
Santiago
Chile
Declarações
CA declares that he has no competing interests.
Créditos aos pareceristas
Os tópicos do BMJ Best Practice são constantemente atualizados, seguindo os desenvolvimentos das evidências e das diretrizes. Os pareceristas aqui listados revisaram o conteúdo pelo menos uma vez durante a história do tópico.
Declarações
As afiliações e declarações dos pareceristas referem--se ao momento da revisão.
Referências
Principais artigos
Snook J, Bhala N, Beales ILP, et al. British Society of Gastroenterology guidelines for the management of iron deficiency anaemia in adults. Gut. 2021 Nov;70(11):2030-51.Texto completo Resumo
Ko CW, Siddique SM, Patel A, et al. AGA clinical practice guidelines on the gastrointestinal evaluation of iron deficiency anemia. Gastroenterology. 2020 Sep;159(3):1085-94.Texto completo Resumo
Kulasekararaj A, Cavenagh J, Dokal I, et al. Guidelines for the diagnosis and management of adult aplastic anaemia: a British Society for Haematology guideline. Br J Haematol. 2024 Mar;204(3):784-804.Texto completo Resumo
Bain BJ, Daniel Y, Henthorn J, et al. Significant haemoglobinopathies: a guideline for screening and diagnosis. Br J Haematol. 2023 Jun;201(6):1047-65.Texto completo Resumo
Artigos de referência
Uma lista completa das fontes referenciadas neste tópico está disponível aqui.
O uso deste conteúdo está sujeito ao nosso aviso legal